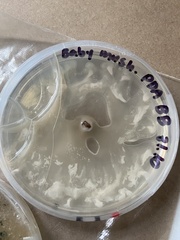
Saccharomycotina

Saccharomycotina: taxon details and analytics
- Domain
- Kingdom
- Fungi
- Phylum
- Ascomycota
- Class
- Order
- Family
- Genus
- Species
- Scientific Name
- Saccharomycotina
Summary description from Wikipedia:
Saccharomycotina in languages:
- Bokmål
- ekte gjærsopper
- English
- budding yeasts
Images from inaturalist.org observations:
We recommend you sign up for this excellent, free service.
Parent Taxon
Sibling Taxa
- Actinocladium
- Acumispora
- Alysidiopsis
- Amblyosporium
- Ameroconium
- Anaselenosporella
- Anaseptoidium
- Angulospora
- Anthina
- Arachnophora
- Arborillus
- Ardhachandra
- Aristastoma
- Arthrobotryella
- Arthrobotryum
- Arthrosporium
- Arthrowallemia
- Articularia
- Ascochytulina
- Asteromyces
- Bactrodesmiella
- Basramyces
- Belemnospora
- Beniowskia
- Biflua
- Brachydesmiella
- Briansuttonia
- Camarographium
- Candelabrum
- Carrismyces
- Ceratocladium
- Ceratophorum
- Ceratosporella
- Chaetendophragmia
- Chaetopsis
- Chaetoseptoria
- Chalarodes
- Cheilaria
- Chromosporium
- Chuppia
- Ciliophora
- Cladoniicola
- Clypeopycnis
- Colletosporium
- Coniambigua
- Coniomela
- Coniothecium
- Coniothyrina
- Coremiella
- Cornucopiella
- Cornutispora
- Corynesporopsis
- Cryptophialoidea
- Cryptosporium
- Culicidospora
- Cumulospora
- Cylindrophora
- Cytonaema
- Cytosporella
- Cytosporina
- Davisiella
- Dearnessia
- Delortia
- Delphinella
- Dendrographium
- Dendrospora
- Dendrosporium
- Dendryphiosphaera
- Denticularia
- Diaphanium
- Dichotomophthora
- Dichotomophthoropsis
- Dicoccum
- Didymochaeta
- Diplocladiella
- Diplodiella
- Diplosporonema
- Discogloeum
- Discosporium
- Drepanospora
- Dwayabeeja
- Ectostroma
- Elotespora
- Enthallopycnidium
- Epaphroconidia
- Everhartia
- Everniicola
- Fairmaniella
- Flabellospora
- Flosculomyces
- Fumago
- Fusella
- Fusichalara
- Fusidium
- Fusoma
- Geohypha
- Gloeodes
- Gloiosphaera
- Gonatobotryum
- Goniopila
- Grallomyces
- Guedea
- Gyrophthorus
- Gyrothrix
- Hadrosporium
- Hansfordia
- Haplobasidion
- Harpographium
- Hawksworthiana
- Helicoceras
- Helicorhoidion
- Helicostilbe
- Henicospora
- Hormiactella
- Hormiactis
- Hyalosynnema
- Hyalothyridium
- Hyalotrochophora
- Hymenella
- Hymenopsis
- Hymenula
- Hypha
- Hyphodiscosia
- Hypodermium
- Janetia
- Kalchbrenneriella
- Karsteniomyces
- Ketubakia
- Lacellina
- Lateriramulosa
- Lawalreea
- Leightoniomyces
- Leptothyrina
- Leptothyrium
- Lichenohendersonia
- Lichenopuccinia
- Linkosia
- Linodochium
- Lylea
- Magdalaenaea
- Mauginiella
- Melanocephala
- Metadiplodia
- Minutoexcipula
- Miricatena
- Mixtoconidium
- Monodidymaria
- Monosporium
- Monotospora
- Moorella
- Morrisographium
- Mycoenterolobium
- Myriellina
- Mystrosporium
- Myxosporium
- Naemosphaera
- Naemospora
- Nematogonum
- Nematographium
- Neophoma
- Neottiospora
- Neta
- Nigropuncta
- Olpitrichum
- Oncopodium
- Orphanocoela
- Paliphora
- Parabeltrania
- Paradiscula
- Patriciomyces
- Penzigomyces
- Perelegamyces
- Periola
- Pestalozziella
- Pezizomycotina
- Phaeocandelabrum
- Phaeostalagmus
- Phaeotrichoconis
- Phragmospathula
- Physalidiella
- Piggotia
- Piricaudilium
- Pirostoma
- Plenozythia
- Pleurodomus
- Pleurotheciopsis
- Pleurothyrium
- Pleurovularia
- Polycladium
- Pseudoacrodictys
- Pseudocenangium
- Pseudoclathrosphaerina
- Pseudodiplodia
- Pseudohansfordia
- Pseudopetrakia
- Pseudostilbella
- Pseudostracoderma
- Pseudotorula
- Refractohilum
- Rhexoacrodictys
- Rhinotrichella
- Rhinotrichum
- Roscoepoundia
- Saccharomycotina
- Sadasivania
- Schroeteria
- Septocyta
- Septogloeum
- Septopatella
- Septosporium
- Septotrullula
- Solicorynespora
- Solosympodiella
- Spermospora
- Spermosporella
- Sphaeronaema
- Spiropes
- Spondylocladiopsis
- Stegilla
- Stenocephalopsis
- Stigmatea
- Subulispora
- Synnematomyces
- Taeniolina
- Talpapellis
- Taphrinomycotina
- Teratosperma
- Tetracoccosporium
- Tetranacrium
- Tompetchia
- Tretospeira
- Tricellula
- Trichoconis
- Tridentaria
- Triramulispora
- Triscelophorus
- Trisulcosporium
- Ulocoryphus
- Vanakripa
- Veramycella
- Virgariella
- Vouauxiella
- Weissia
- Weufia
- Xylohypha
- Zebrospora
- Zelandiocoela